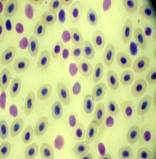

Биологические науки/8.Физиология
человека и животных
Кузина Т.В.
ФГУП "Каспийский
научно-исследовательский институт рыбного хозяйства"
Россия, г.
Астрахань
Гематологические
показатели судака Stizostedion lucioperca Волго-Каспийского канала
Система кроветворения рыб чутко реагирует
на воздействие факторов окружающей среды. Известно, что нарушение
физиологического состояния организма рыб под действием токсического агента
отражается на гематологических показателях. При патологических состояниях в
крови рыб регистрируются морфологически измененные клеточные элементы.
Изменения в крови рыб возникают в ответ на действие загрязняющих веществ, даже,
если их концентрация не превышает ПДК, тем более что действие различных
токсикантов может суммироваться и усиливаться. Суммарный генотоксический эффект
может быть учтен путем микроядерного тестирования. Эффект воздействия
генотоксикантов проявляется в виде индукции микроядер (МЯ) в эритроцитах
периферической крови рыб (4, 5).
Целью
исследования является использование
гематологических показателей крови рыб в качестве критерия суммарного
загрязнения вод Нижней Волги и как одного из элементов в системе комплексного
биологического мониторинга водных экосистем. Исследования выполнены на
репрезентативных выборках клеток тестовых объектов: эритроцитах периферической
крови судака Stizostedion lucioperca.
Лов рыбы для анализа производился осенью 2006, 2007 гг. на тоневом участке
Волго-Каспийского канала. Для гематологического анализа использовали рыб без
видимых внешних повреждений и проявлений каких-либо заболеваний. Объём выборки
в большинстве случаев составлял 25 экземпляров. Определяли СОЭ, концентрацию
гемоглобина, количество эритроцитов, процентное соотношение лейкоцитов на
мазках периферической крови, окрашенных азур-эозином по Романовскому.
Количественное соотношение патологически измененных форменных элементов крови
(ФЭК) определяли согласно рекомендациям Житеневой Л.Д. с соавт. (2). Для оценки
генотоксического влияния суммарных факторов среды мазки периферической крови фиксировали
этанолом и окрашивали красителем Гимза. На препаратах проводили учет
эритроцитов с микроядрами (МЯ) и другими фенотипическими нарушениями ядра.
Определяли долю клеток с МЯ и другими типами патологии ядра по отношению к
общему количеству проанализированных эритроцитов. Статистическую оценку
результатов проводили с помощью метода альтернативного анализа и критерия
Стьюдента.
Результаты
и обсуждение. Осенью 2006 г. были отмечены
более низкие показатели: гемоглобина, количество эритроцитов, СОЭ, по сравнению с 2007 г. Характеристика физического состояния рыб и
периферической крови судака приведена в таблице 1.
Таблица 1- Гематологические показатели
физиологического состояния судака
(осенний период исследования)
|
Показатели |
2006 г. |
2007 г. |
|||
|
Условная норма |
M± m, n=25 экз |
σ |
M± m, n=25 |
σ |
|
|
Промысловая длина, см |
|
39,50±0,57 |
2,78 |
41,27±1,05 |
3,50 |
|
Масса тела, г |
|
878,80±46,40 |
227,10 |
980,45±75,87 |
251,63 |
|
Показатели периферической крови: |
|||||
|
Hb, г/л |
70,00-72,00 |
61,88±2,19 (n=24) |
10,70 |
75,04±2,21 |
11,03 |
|
СОЭ, мм |
|
1,77±0,25 (n=24) |
1,24 |
1,48±0,14 |
0,71 |
|
Количество эритроцитов *1012 в л |
1,70-1,85 |
1,30±0,10 (n=11) |
0,32 |
1,84±0,08 |
0,42 |
|
СГЭ, пг |
22,40-42,20 |
47,81±2,73 (n =11) |
9,06 |
38,92±1,62 |
8,13 |
|
Псевдоэозинофилы, % |
|
0,42±0,17 |
0,89 |
0,04 ± 0,03 |
0,14 |
|
Псевдобазофилы,
% |
|
0,52±0,17 |
0,85 |
- |
- |
|
Нейтрофилы,
% |
0,10-2,00 |
4,04±1,34 |
6,72 |
11,86±4,42 |
22,11 |
|
Лимфоциты,
% |
94,70-95,60 |
93,02±1,34 |
6,69 |
83,63±5,04 |
25,20 |
|
Полиморфноядерные
лейкоциты, % |
0,20-0,60 |
1,80±0,35 |
1,77 |
- |
- |
|
моноциты,
% |
3,30-4,40 |
0,10±0,06 |
0,29 |
3,38±0,71 |
3,53 |
Однако насыщение
гемоглобином эритроцитов (СГЭ, пг) соответствовало норме у всех исследованных
рыб как в 2006, так и 2007 г. При
исследовании периферической крови рыб, был обнаружен ряд изменений клеток
красного ряда, отличающихся степенью проявления патоморфологических нарушений
(таблица 2). Осенью 2006 г. у всех рыб доля молодых форм эритроцитов в среднем составляла 3,0-4,0 %, а 2007 г. –
2,0-3,0%. Размер клеток у большинства рыб находился в пределах физиологической
нормы (2). Частота встречаемости рыб с анизоцитозом эритроцитов осенью 2007 г.
увеличилась в 2 раза, по сравнению с
2006 г. и составила 16,0%. На мазках крови рыб выявлено значительное
количество разрушенных клеток и эритроцитов в предгемолитическом состоянии.
Таблица 2 - Частота встречаемости морфологических
нарушений в эритроцитах судака, %
|
Отмеченные
нарушения |
Осень 2006 |
Осень 2007 |
|
Анизоцитоз
(разноразмерность) |
8,0 |
16,0 |
|
Пойкилоцитоз (изменение формы) |
32,0 |
33,0 |
|
Агглютинация |
12,0 |
4,0 |
|
Нарушение осморезистентности |
76,0 |
75,0 |
|
Шистоциты |
4,0 |
25,0 |
|
Амитоз |
32,0 |
4,0 |
|
Кариорексис |
20,0 |
17,0 |
|
Разрушенные
эритроциты |
32,0 |
88,0 |
|
Вакуолизация |
12,0 |
29,0 |
|
Количество исследованных особей |
25 |
24 |
В 2007 г., процесс, заключающийся в распаде клетки, составил 88,0%
от общего числа исследованных клеток (рисунок 1,г). Подобные явления, как
правило, возникают в результате воздействия неблагоприятных условий как вне,
так и внутри организма (например, интоксикация различной этиологии). В 2007
г.был зарегистрирован высокий процент (25,0%) безъядерных эритроцитов
(шистоцитов), образующихся вследствие
атипичного деления клетки (рисунок 1, в). Пойкилоцитоз эритроцитов (2006г. – 32,0%, 2007г. – 33,0%) был
выражен полигональностью клеток. Отмечали клетки грушевидной, серповидной,
ромбовидной формы с заостренными краями (рисунок 1, д). Изменение формы
эритроцитов свидетельствует о снижении эластичности клеточной оболочки. У всех
исследованных рыб наблюдали нарушение осмотической резистентности мембраны
эритроцитов в легкой форме, т.е. не исключена обратимость данного процесса (рисунок
1, б). Деструктивные изменения ядер эритроцитов крови судака характеризовались их деформацией (полиморфизм), пикнозом, инвагинацией (вследствие нарушения
резистентности ядерной оболочки), наличием пристеночных ядер. Явление
кариорексиса носило более выраженный характер, как по встречаемости признака,
так и по степени его проявления, в осенний период 2006 г. (2006 – 20,0%, 2007 –
17,0%).
|
|
|
|
||||
|
а |
б |
|||||
|
|
|
|
|
|||
|
в |
г |
|||||
|
|
|
|
||||
|
д |
||||||
|
Рисунок 1 - Морфологические нарушения эритроцитов
(×1000) а)вакуолизация, б)нарушение эластичности
эритроцитарной мембраны, в)шистоциты,
г)разрушение эритроцитов, д)пойкилоцитоз |
||||||
В 2006, 2007 гг. в белой крови рыб преобладали
лимфоциты (93,0%, 83,0% соответственно), но находились в пределах условной
нормы (9, 10). При этом, осенью 2006 г. гранулярные формы лейкоцитов были
представлены, псевдобазофилами (ПБФ), нейтрофилами и псевдоэозинофилами (ПЭФ),
последние встречались в основном, на
стадии миелоцита, т.е. молодой клетки, обладающей незначительной функциональной
активностью. В 2007 г. псевдобазофилы отсутствовали (таблица 1).
Основной функцией нейтрофилов является защита
организма от инфекций, токсического воздействия, как правило, они проявляют
себя как фагоциты. Все функции нейтрофилы начинают выполнять на стадии
палочкоядерной формы (2,3). Осенью 2007 г. процент нейтрофилов возрос (11,86%)
по сравнению с 2006 г. (4,04%). Таким образом стабилизация всех показателей
крови судака в 2007 г. свидетельствует об улучшении физиологического состояния
рыбы и, как следствие этого, повышении их иммунитета.
Исследования
МЯ (рисунок 2) относится к одному из наиболее важных и быстрых тестов выявления мутагенного
действия биотических и абиотических факторов на организм рыб (1,8). Микроядра
(МЯ), в основном, образуются из хромосомного материала, лишенного центромеры, в
процессе образования аберраций хромосом и потому отставшего на стадии анафазы
от общего числа расходящихся хромосом. В ходе митоза этот материал попадает
лишь в одну из дочерних клеток и формирует одно или несколько МЯ. Разница долей
эритроцитов с МЯ в периферической крови рыб, с отклонениями от условной нормы
по гематологическим показателям, с экземплярами рыб относительно здоровыми
является достоверной (р < 0,05, табл. 4).
|
|
|
|
|
Рисунок 2 Микроядра в эритроцитах периферической
крови судака (×5000) |
||
У рыб, гематологические показатели (СОЭ, Hb, кол-во эритроцитов в литре) которых соответствовали
физиологическим нормам, доля эритроцитов с МЯ и другими нарушениями ядра
составила 1,0-1,5%. Достоверного различия частоты встречаемости микроядер в
эритроцитах периферической крови рыб, различающихся по полу, не установлено.
Таблица 4 - Частота встречаемости микроядер и других
фенотипических нарушений ядра в эритроцитах судака 2007г.
|
Показатели |
Лето |
Осень |
||
|
M±m |
Предел варьирования, от-до |
M±m |
Предел варьирования, от-до |
|
|
Эритроциты с МЯ |
9,22±1,58 |
2-24 |
25,33±3,87* |
7-89 |
|
Эритроциты
с др. нарушениями ядра |
8,50±1,79 |
1-27 |
12,83±0,87* |
5-21 |
|
Кол-во обследованных
рыб |
18 |
24 |
||
|
Кол-во
проанализированных клеток |
28500 |
24000 |
||
Примечание * р< 0,01
В целом, проведенный цитопатологический анализ клеток
периферической крови судака в осенние периоды 2006 и 2007гг. позволил выявить
наиболее значимые для здоровья рыб изменения. Это пойкилоцитоз эритроцитов,
повреждение эритроцитов вызванное нарушением их осморезистентности – явления
характерные для наличия негативного фактора воздействия (химическое влияние,
заболевания различной этиологии). Можно предположить, что характер отмеченных
изменений связан с нарушениями эритроцитарной мембраны при контакте с веществами,
обладающими повреждающим действием, при этом не исключается обратимость этих
процессов. Отмеченные изменения в соотношении различных форм лейкоцитов,
представленные невысоким содержанием фагоцитов (моноциты), осенью 2006 г. и
увеличением количества нейтрофилов в 2007 г.,
могут объясняться как физиологическими особенностями рыб, так и
токсическим воздействием на организм рыб загрязняющих веществ вод Волго-Каспия.
Обнаруженное повышенное количество микроядер в эритроцитах периферической крови
судака свидетельствует о потенциальной мутагенности воды Волго-Каспийского
канала.
Список литературы
1. Давыдов О.Н., Темниханов Ю.Д., Куровская Л.Я. Патология крови рыб.
-Фирма «ИНКОС», 2006. - 206 с.: ил., 12
цв.ил.
2. Житенева Л.Д., Полтавцева Т.Г., Рудницкая О.А. Атлас нормальных и
патологически измененных клеток крови рыб.- Ростов-на-Дону: Кн. изд-во,
1989.-112 с.
3. Иванова Н.Т. Атлас клеток крови рыб (сравнительная морфология и
классификация форменных элементов крови рыб).- М.: Легкая и пищевая пром-сть,
1983.- 184 с.
4. Изюмов Ю.Г., М.Г. Таликина, Ю.В. Чеботарева Количество микроядер в
эритроцитах периферической крови плотвы Rutilus rutilus и леща Abramis brama Рыбинского и Горьковского водохранилищ // Биология внутренних вод, 2003
№1, с.98-101.
5. Ильинских Н.Н. Использование микроядерного теста в скрининге и
мониторинге мутагенов // Цитология и генетика, 1988 Т.22 №1, с.67-71.
6. Кошулин Н.А., Лукин А.А., Амонтсен П.А. Рыбы пресных вод Субарктики как
биоиндикаторы техногенного загрязнения.- Апатиты.- 1999.- 142 с.
7. Методические указания по гематологическому обследованию рыб в водной
токсикологии //Составил Крылов О.Н.-Л.: Изд-во ГосНИОРХ, 1974.- 40.с.
8. Моисеенко Т.И. Гематологические показатели рыб в оценке их токсикозов
(на примере сига Coregonus lavaretus) // Вопросы ихтиологии, 1998 №3, с.371-380.
9. Справочник по физиологии рыб/ А.А. Яржомбек, В.В. Лиманский, Т.В.
Щербина с соавт.; Под.ред. А.А. Яржомбека.-М.: Агропромиздат, 1986.- 192 с.
10.Эколого-гематологические
характеристики некоторых видов рыб. Справочник / Л.Д. Житенева, О.А. Рудницкая,
Т.И. Калюжная. – Ростов-на-Дону: Изд-во
«Молот», 1997. – 152с.